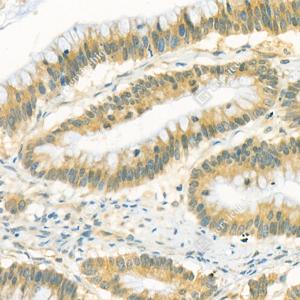

Anti-PNPLA8 Rabbit pAb
- 100 μL
产品信息
|
蛋白质全称 |
钙非依赖磷脂酶A2-γ |
|
别名 |
IPLA2-2, IPLA2G, iPLA2gamma |
|
Uniprot ID |
Q8K1N1 |
|
免疫原 |
小鼠Pnpla8重组蛋白 |
|
抗体亚型 |
IgG |
|
纯化方式 |
亲和纯化 |
|
亚细胞定位 |
内质网, 膜, 线粒体, 过氧化物酶体 |
应用
| 应用 | 物种 | 稀释 | 阳性样品 |
| IHC/IF 免疫组织化学/免疫荧光 | 人 | 1: 600-1: 1200 | 结肠癌, 食管癌, 胃癌 |
背景
Calcium-independent and membrane-bound phospholipase, that catalyzes the esterolytic cleavage of fatty acids from glycerophospholipids to yield free fatty acids and lysophospholipids, hence regulating membrane physical properties and the release of lipid second messengers and growth factors.Hydrolyzes phosphatidylethanolamine, phosphatidylcholine and probably phosphatidylinositol with a possible preference for the former. Has also a broad substrate specificity in terms of fatty acid moieties, hydrolyzing saturated and mono-unsaturated fatty acids at nearly equal rates from either the sn-1 or sn-2 position in diacyl phosphatidylcholine. However, has a weak activity toward polyunsaturated fatty acids at the sn-2 position, and thereby favors the production of 2-arachidonoyl lysophosphatidylcholine, a key branch point metabolite in eicosanoid signaling.
图像
|
|
IHC检测PNPLA8蛋白(货号 GB114434). 样品: 人结肠癌, 4%多聚甲醛 (货号G1101) 固定12-24小时. 抗原修复: 柠檬酸抗原修复液(干粉, pH 6.0) (G1201), 98℃, 20分钟. —抗: 1: 600稀释, 4℃ 孵育过夜. 二抗: HRP标记山羊抗兔IgG (H+L) (货号GB23303), 1: 200稀释, 室温孵育1小时. |
|
|
IHC检测PNPLA8蛋白(货号 GB114434). 样品: 人食管癌, 4%多聚甲醛 (货号G1101) 固定12-24小时. 抗原修复: 柠檬酸抗原修复液(干粉, pH 6.0) (G1201), 98℃, 20分钟. —抗: 1: 600稀释, 4℃ 孵育过夜. 二抗: HRP标记山羊抗兔IgG (H+L) (货号GB23303), 1: 200稀释, 室温孵育1小时. |
|
|
IHC检测PNPLA8蛋白(货号 GB114434). 样品: 人胃癌, 4%多聚甲醛 (货号G1101) 固定12-24小时. 抗原修复: 柠檬酸抗原修复液(干粉, pH 6.0) (G1201), 98℃, 20分钟. —抗: 1: 600稀释, 4℃ 孵育过夜. 二抗: HRP标记山羊抗兔IgG (H+L) (货号GB23303), 1: 200稀释, 室温孵育1小时. |
储存
| 储存条件 | 在-20℃下储存一年, 避免反复冻融. |
| 储存缓冲液 | 含0.15% ProClin300防腐剂, 100 μg/mL牛血清白蛋白和50%甘油的磷酸盐缓冲液. |
注意:
1.本产品仅供研究使用.
2.建议用一抗稀释液(G2025)稀释本产品.
| 货号 | 名称 | 规格 | 价格 | 操作 |
|---|
| 货号 | 名称 | 规格 | 价格 | 操作 |
|---|